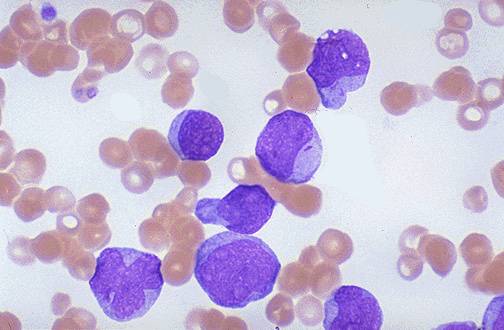

Acute Myelogenous Leukemia
 Acute
Myelogenous Leukemia is most common in older people because it is a
genetic abnormality that is acquired during a person’s life and not
inherited from their parents. Radiation and chemotherapy increase the
risk of a person developing AML, but some genetic disorders such as
Down’s Syndrome and Fanconi anemia can increase the risk as well.
Sometimes a higher than normal rate of leukemia is found in a
particular family. They may have inherited an increased
susceptibility to AML. When the person acquires the damage to the DNA
of developing bone marrow cells it causes uncontrolled, quickened
growth and the production of normal cells is blocked (Leukemia and
Lymphoma Society, 2005).
Acute
Myelogenous Leukemia is most common in older people because it is a
genetic abnormality that is acquired during a person’s life and not
inherited from their parents. Radiation and chemotherapy increase the
risk of a person developing AML, but some genetic disorders such as
Down’s Syndrome and Fanconi anemia can increase the risk as well.
Sometimes a higher than normal rate of leukemia is found in a
particular family. They may have inherited an increased
susceptibility to AML. When the person acquires the damage to the DNA
of developing bone marrow cells it causes uncontrolled, quickened
growth and the production of normal cells is blocked (Leukemia and
Lymphoma Society, 2005).
Incidence: In the United States, there are
about 9,000 - 11,960 individuals who get AML each year (Robien and
Ulrich, 2003).
Prevalence in children: About 20% of the cases
of childhood leukemia are due to AML(Robien and Ulrich, 2003).
Average age at onset: AML is primarily a
disease of the elderly. 65 is the median age at which patients are
diagnosed with AML, and it is most prevalent in the post-retirement
decades (Robien, Ulrich 30). The risk of developing AML increases
rapidly as a person reaches 40. In the 30-34 age range, about 1
person per 100,000 people develops AML. People in the 65-69 age range
are ten times more likely to develop AML, with 1 in 10,000 becoming
ill (Leukemia and Lymphoma Society, 2005).
Specific risk factors: The cause of AML is not
clear, but the condition has been linked to several environmental
factors, including exposure to: high doses of irradiation, the
chemical benzene, chemotherapy (particularly alkylating agents and
topoisomerase inhibitors), and therapeutic radiation. Some rare
genetic conditions, including “Fanconi anemia, Schwachman-Diamond
syndrome, Down syndrome,” “Bloom's syndrome, and ataxia
telangiectasia” increase the risk of developing AML. AML sometimes
seems to run in families (Leukemia and Lymphoma Society, 2005).
Home
References
Cited
Created by Shannon McGlauflin, Jolene Munger, and
Rebecca Nelson, 2005.
Acute
Myelogenous Leukemia is most common in older people because it is a
genetic abnormality that is acquired during a person’s life and not
inherited from their parents. Radiation and chemotherapy increase the
risk of a person developing AML, but some genetic disorders such as
Down’s Syndrome and Fanconi anemia can increase the risk as well.
Sometimes a higher than normal rate of leukemia is found in a
particular family. They may have inherited an increased
susceptibility to AML. When the person acquires the damage to the DNA
of developing bone marrow cells it causes uncontrolled, quickened
growth and the production of normal cells is blocked (Leukemia and
Lymphoma Society, 2005).
Acute
Myelogenous Leukemia is most common in older people because it is a
genetic abnormality that is acquired during a person’s life and not
inherited from their parents. Radiation and chemotherapy increase the
risk of a person developing AML, but some genetic disorders such as
Down’s Syndrome and Fanconi anemia can increase the risk as well.
Sometimes a higher than normal rate of leukemia is found in a
particular family. They may have inherited an increased
susceptibility to AML. When the person acquires the damage to the DNA
of developing bone marrow cells it causes uncontrolled, quickened
growth and the production of normal cells is blocked (Leukemia and
Lymphoma Society, 2005).